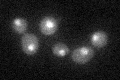
YBR289W
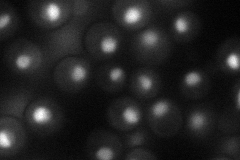
YBR289W
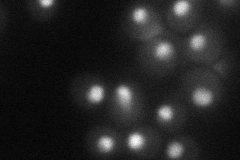
YBR289W
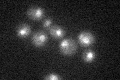
YBR289W

View description
Subunit of the SWI/SNF chromatin remodeling complex involved in transcriptional regulation; functions interdependently in transcriptional activation with Snf2p and Snf6p
Localization:
Intensity:
Fold change:
Significance:
-
C’ GFP library in SD
nucleus25.15 -
N' NOP1pr-GFP in SD
nucleolus49.0645 -
N' TEF2pr-mCherry in SD
nucleus32.7381 -
N' NATIVEpr-GFP in SD

missing0 -
N' TEF2pr-VC and Cyto-VN in SD

below threshold24.9083 -
C’ GFP library in SD+DTT

nucleus21.150.84No -
C’ GFP library in SD+H2O2

nucleus26.091.03No -
C’ GFP library in Starvation Media
nucleus22.050.87No -
C’ GFP library on the background of Pup2-DaMP

nucleus -
C’ GFP library on the background of CCT mutant

nucleus25.93831.03091No
